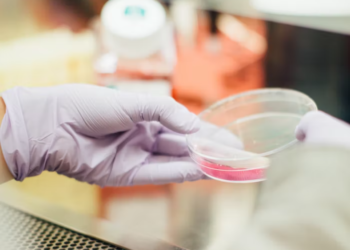
السلطات الصحية في ميشغان تؤكد تسجيل 43 إصابة بالإشريكية القولونية

أخبار امريكا
الولايات الأمريكية الأقل والأعلى تكلفةً بالنسبة لإنجاب طفل
صنفت دراسة جديدة من QuoteWizard بواسطة شركة LendingTree أغلى الولايات وأقلها تكلفة بالنسبة لإنجاب طفل في الولايات المتحدة. حيث قارنت...
اقرأ المزيدديربورن هايتس تستضيف حدث الهدية المجانية للصحة و حقيبة الظهر يوم 24 آب/أغسطس
يقيم Bill Bazzi عمدة ديربورن هايتس مع منظمة الإغاثة الطبية العالمية و 16 من مقدمي الرعاية الصحية و الخدمات البشرية...
اقرأ المزيدحكم يفرض على Highland Park دفع فاتورة مياه تتجاوز 20 مليون دولار!
أعاد حكم من محكمة الاستئناف فرض فاتورة مياه غير مدفوعة بقيمة 21 مليون دولار على مدينة Highland Park، و هو...
اقرأ المزيدمخاوف كبيرة بشأن المعاملة غير العادلة من قبل شركات التأمين ضد العرب والكلدان الأمريكيين
يمكن القول أن مشاكل العداء العرقي والديني تشكل تحديات مستمرة لأبناء ميشيغان الذين ينحدرون من أصول مختلفة سواء من الشرق...
اقرأ المزيدارتفاعٌ في معدل جرائم سرقة محتويات السيارات في ديربورن هايتس
كشفت مدينة ديربورن هايتس عبر بيانٍ صحفي أن شرطة المدينة تلقت في الآونة الأخيرة عدداً متزايداً من شكاوى السكان الذين...
اقرأ المزيدالسلطات الصحية في ميشغان تؤكد تسجيل 43 إصابة بالإشريكية القولونية
أكدت السلطات الصحية في ميشغان تسجيل 43 إصابة بالإشريكية القولونية تطابق سلالة الإشريكية القولونية O157. حيث تم الأبلاغ عن أكثر...
اقرأ المزيدمراكز الرعاية النهارية تساعد الأهالي الذين يعملون خارج أوقات وظائفهم
يواجه العديد من الآباء صعوبة في العثور على رعاية نهارية تناسب جداول العمل غير النمطية مع عودة الطلاب إلى المدرسة....
اقرأ المزيدوكالة الأبحاث Fitch :إمكانية حدوث ركود حاد في سوق الإسكان كبيرة
وفقاً لتقرير جديد صادر عن وكالة التصنيف الائتماني ووكالة الأبحاث Fitch، فقد زادت إمكانية حدوث ركود حاد في سوق الإسكان...
اقرأ المزيدهل يمكن أن يساعد التحول إلى الأسبوع المدرسي لمدة أربعة أيام في معالجة نقص المعلمين؟
مدينة صغيرة في نيو مكسيكو من بين عدد من المناطق التعليمية التي تحولت إلى أسبوع مدرسي مدته أربعة أيام كوسيلة...
اقرأ المزيدامرأة تبلغ من العمر 67 عام تربح مبلغ مليون دولار في يانصيب ميشيغان
فازت امرأة من مقاطعة "ليناوي" تبلغ من العمر 67 عاماً بمليون دولار في إحدى الألعاب الفورية Million Cash Payout من...
اقرأ المزيد